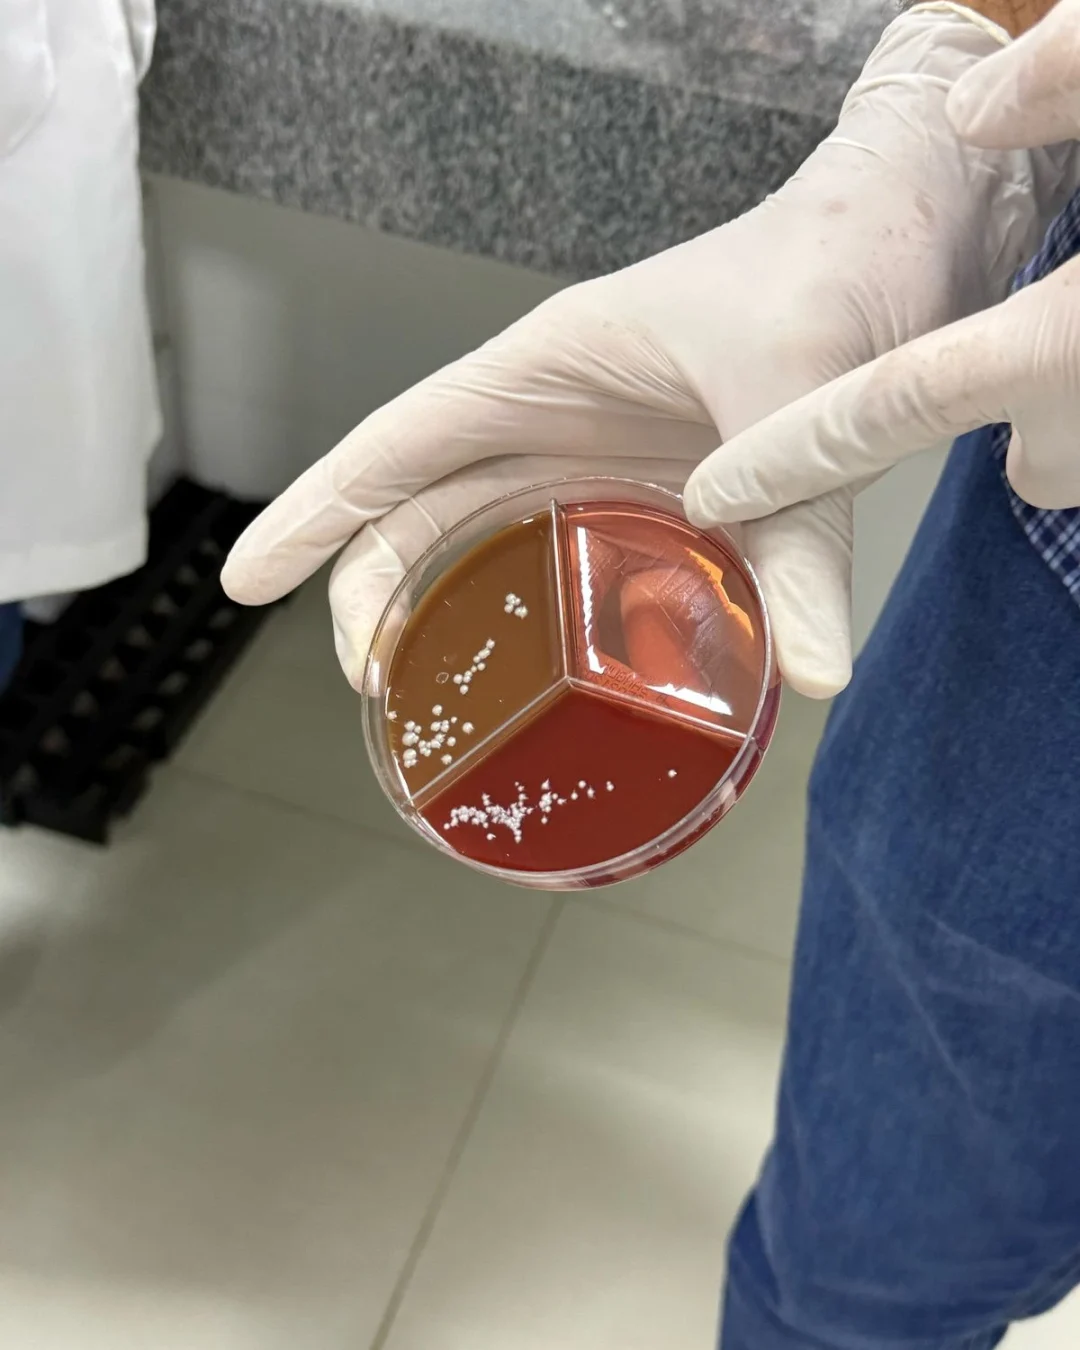
WhatsApp Image 2025-04-28 at 11.53.22 (1)

Instituto de Saúde Aplicada X
Há 8 anos entregando ensinamento em uma abordagem prática. Venha aprender com os maiores experts de Brasília!
Área de interesse:
Tem dúvidas se somos uma boa opção para sua especialização?
Deixe que quem já viveu essa experiência responda por nós.
Veja depoimentos sinceros de alunos que passaram por aqui e hoje atuam com mais segurança e prática no mercado.
E se quiser ir além, você pode agendar uma visita ou até mesmo participar de uma aula experimental para conhecer de perto nossa metodologia.
O ISAX faz por você:
Prática
Com estágios em Clínicas e Laboratórios renomados você sairá daqui um verdadeiro expert.
Certificação
Nossos certificados são válidos pelo MEC, já temos mais de 800 alunos especializados que já atuam no mercado.
Velocidade
Focamos no que importa para você não perder tempo. Ensinamos tudo aquilo que é cobrado e que a faculdade não ensinou!
Pagamento Facilitado
Contamos com parcelamento amigável para levar ensino de qualidade para todos!
Faça parte da família ISAX
Laboratório ou Estética, aqui você tem o seu lugar!

Atendimento no WhatsApp
Mande uma mensagem e receba em seu telefone: e-books, preços, formas de pagamento e muito mais!